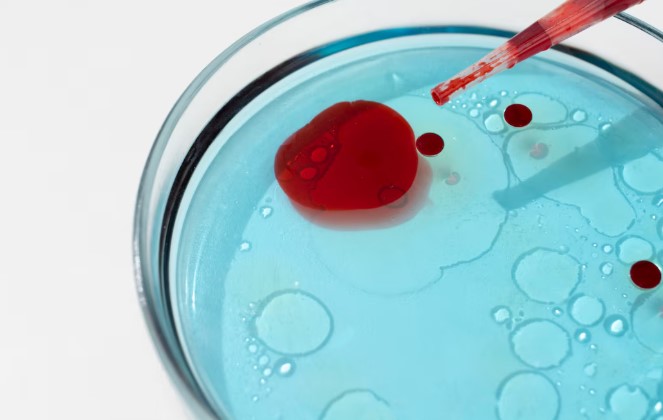

La salud es un derecho, no un privilegio. Sin embargo, para quienes viven con trastornos de la coagulación, el camino puede ser un desafío constante. El Día Mundial de la Hemofilia es la fecha clave para visibilizar esta condición y abogar por un acceso equitativo al cuidado médico.
¿En qué consiste la Hemofilia?
La hemofilia es un trastorno hemorrágico hereditario en el cual la sangre no coagula de manera adecuada. Esto sucede porque el cuerpo no produce suficiente cantidad de unas proteínas llamadas «factores de coagulación» (específicamente el Factor VIII en la Hemofilia A y el Factor IX en la Hemofilia B).
Las personas con hemofilia no sangran más rápido que las demás, pero sí pueden sangrar durante un tiempo más prolongado. Las hemorragias pueden ser externas o, más preocupantes aún, internas (especialmente en articulaciones como rodillas, codos y tobillos), lo que puede causar daño crónico si no se trata.
¿Cuándo se conmemora?
Este día se observa globalmente cada 17 de abril.
¿Quién lo institucionalizó?
Fue instituido por la Federación Mundial de Hemofilia (FMH) en 1989. Se eligió el 17 de abril en honor al aniversario del nacimiento de Frank Schnabel, el fundador de dicha federación, quien dedicó su vida a mejorar la calidad de vida de los pacientes con esta condición.
Importancia de este día
La relevancia de esta conmemoración es profunda:
- Diagnóstico temprano: Muchas personas viven con trastornos de coagulación sin saberlo. Esta campaña ayuda a identificar síntomas.
- Equidad en el tratamiento: En muchos países en desarrollo, el acceso a los concentrados de factor de coagulación es limitado. El día sirve para presionar por mejores políticas de salud.
- Apoyo a la comunidad: Crea una red de apoyo para que los pacientes y sus familias no se sientan solos en su proceso.
¿Cómo se conmemora?
La actividad más emblemática de este día es la campaña «Ilumínate de Rojo».
- Monumentos en rojo: Edificios emblemáticos de todo el mundo (como el Empire State o el Coliseo) se iluminan de color rojo en solidaridad.
- Educación: Se realizan seminarios web y charlas médicas sobre los avances en terapia génica.
- Vestimenta: Se invita a las personas a usar una prenda roja para mostrar su apoyo en redes sociales.
Frase para quienes la padecen
«Tu condición es parte de tu historia, pero no define tu destino. Con cuidado, disciplina y valentía, no hay meta que tu sangre no pueda alcanzar.»
Si esta información te parece interesante, compártela con tus amigos.

También puede interesarte:
Día Mundial del donante de Médula Ósea y Sangre del Cordón Umbilical
Día Mundial del Donante de Sangre
Día Mundial del Donante de Órganos y Tejidos









